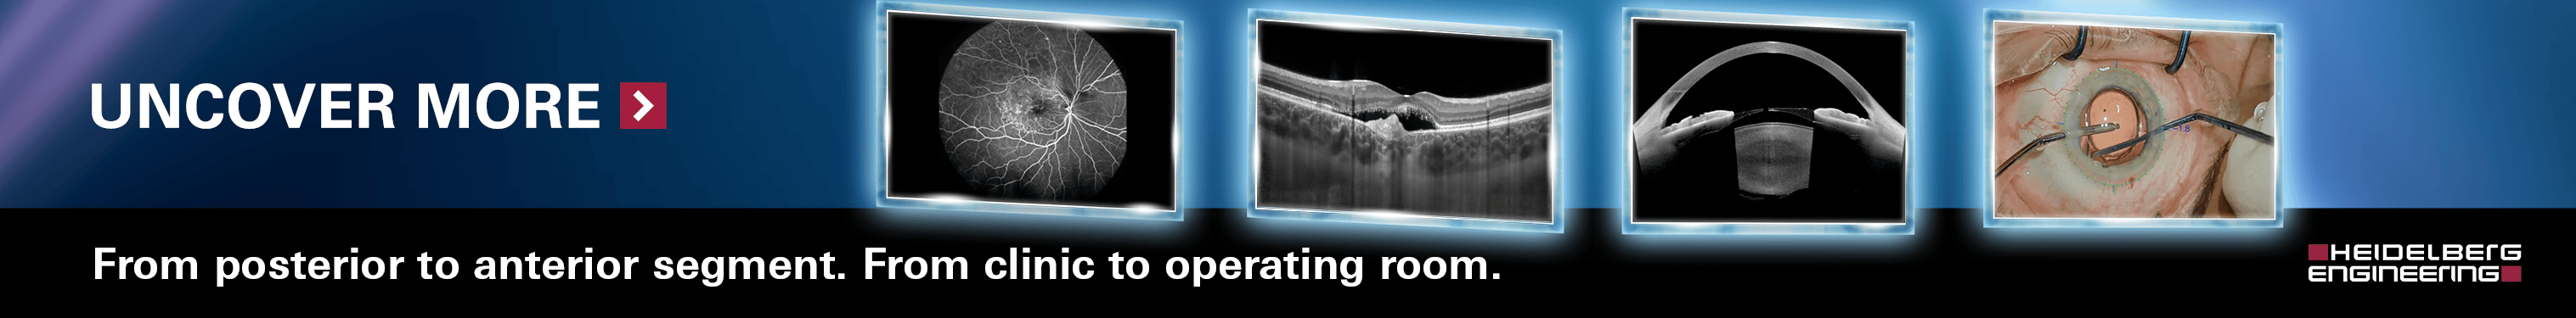
Floretina Banner

Congress
Floretina Icoor Meeting 2026

Information
-
December 03 - December 06, 2026
-
Florence, Fortezza da Basso
-
For info: secretariat@floretina.com
- More information
Webinars, live surgeries and events
Floretina Live
Floretina.com offers a number of live webinars on different topics throughout the year. They are
traditionally planned on Tuesday, at 6.30pm CET/CEST, but if that does not fit with your time
zone, you can always watch the webcast at any time, as we record all sessions and upload them in
the Webinars Archive.
Next events
Past events
Past
surgeries
Focus on
MYOPIA AND RELATED COMPLICATIONS
The incidence in the world of nearsightedness is on the rise. The association with other ocular diseases and the impact of myopia complications are quite frequent. Discover our new section with lessons on medical and surgical topics, webinars on new treatment opportunities.

Video presentation
Surf the presentations on myopia associated diseases held during FLORetina-ICOOR 2025.
Watch now
Interview
Promoted by ZEISS Vision Care, the content features Prof. Paolo Nucci (University of Milan, Italy) and Fabio Briganti (Technical Marketing Manager, ZEISS Vision Care) debating on hot topics on myopia and pre-myopia.
Discover more
June 16, 2025, 6.30 PM CEST
Critical thinking on Myopia and Myopia Progression
Faculty: Dominique Brémond-Gignac, Luca Buzzonetti, Paolo Nucci, Arne Ohlendorf, Isabella Puddu, Giuliano Stramare

Breaking news
Hot topics from editors
The editorial team* at Floretina.com is committed to select the news of the month. We
will interview established physicians, as well as young ophthalmologists, scientific advisors
and Industry representatives. Register on the website to receive news notifications!
*Timothy Norris has been working for ten years in medical communication in
the field of ophthalmology. He regularly collaborates as journalist, medical writer and
copywriter with influential newspapers and specialised agencies, including Ocular
Surgery News, Eyeworld, Retina Today and Media Mice. He is currently working for the
media agency Etcetera Communication.
From prevention to treatment, a joint effort of doctors, family and industry
Feb 25, 2026As part of the global myopia epidemic, early onset-myopia progression is increasingly becoming a pressing and time sensitive issue, due to the increased risks of severe nearsightedness and the related vision impairing consequences. According to the International Myopia Institute, there is a need for a rigorous and evidence-based approach to achieve a deeper understanding of this negative trend. All parts involved, including clinicians, researchers and the industry need to take part in the joint effort of controlling the onset and progression of myopia on a global scale. Read more
Superior Efficiency in Action: Surgeons Share Their Experience with Alcon Unity VCS
Dec 03, 2025Alcon, the global leader in eye care, will showcase its latest innovation for cataract and vitreoretinal surgery at the FLORetina-ICOOR 2025 Congress in Florence, Italy, December 4-7. Floretina delegates are invited to attend live surgery sessions and visit the Alcon booth to find out more about UNITY® VCS, a versatile platform that offers two configurations: the combined Vitreoretinal Cataract System (VCS) and the standalone Cataract System (CS). Read more
Floretina-Icoor
Scientific news

Editorials
Optic disc neovascularization (NVD) associated with pediatric uveitis
Purpose: To describe the clinical presentation and outcomes of optic disc neovascularization (NVD) associated with pediatric uveitis treated with adalimumab. Read more
Diabetic macular edema: OCT retinal biomarkers as predictive factors of treatment response and long-term visual outcome
Diabetic retinopathy (DR) is the leading cause of blindness in working-aged people worldwide[1]. Diabetic macular edema (DME) occurs in nearly 12% of patients with DR and represents a frequent complication of diabetes resulting from disruption of blood-retinal barrier and accumulation of fluid in the retina, which can lead to significant central visual loss if left untreated[2]. Read more
Floretina
Videolibrary
This section features the video recordings of
- the live surgery sessions held during the past editions of Floretina Meetings
- the live surgery sessions webcasted from a specific Centre
Search video
Live surgery from meetings
Live surgery from streaming
Floretina.com will be also happy to publish surgical videos submitted by users:
we welcome you to upload yours
Send your videoFloretina
Lecture from past meetings
Search Lecture

The repository of retina images
Image bank
We welcome professionals, researchers, industry contributors who are registered on Floretina.com to upload and share their diagrams and figures illustrating retinal anatomy or clinical techniques, case series, and ultrasound images. Please read our terms of use and upload your picture.
View the image banks Send your image banksSearch image bank
Rickettsial retinitis
Rickettsial infections are caused by a variety of obligate intracellular, Gram-negative bacteria. Ocular involvement is common but often asymptomatic. All ocular structures can be involved, but posterior segment involvement is more common and most severe. Common posterior segment manifestations are inner retinitis with associated vasculitis and mild vitritis. There are various speculations regarding the pathogenesis of rickettsial retinitis. The cotton wool spot-like retinal lesions could result from intraretinal multiplication of organisms or alternatively due to immune complex deposition along retinal vessels.
VIEW IMAGE BANKLetrozole-induced unilateral acute intermediate uveitis with cystoid macular edema
A case of 48 y/o lady who presented with DOV in RE (6/60) since 15 days. She had a h/o Ca right breast treated with mastectomy 13 years back & was prescribed letrozole(AROMATASE INHIBITOR) 2.5mg OD as she had tested ER +ve. Anterior segment showed cells in AC & anterior vitreous face. Posterior segment revealed disc & macular edema. OCT also showed disc edema & CME. LE examination was WNL. Systemic investigations were WNL. She was asked to stop letrozole after oncology consultation & was prescribed topical prednisolone & nepafenac. Discontinuation of letrozole improved visual acuity to 6/18 within 1 month.
VIEW IMAGE BANKRetained iofb presenting as vitreous haemorrhage
Patient presented with dimunition of vision in right eye,on evaluation patient had re- vitreous haemorrhage,on imaging iofb noted. Planned ppv and metallic iofb removed with the help of maxgrip forceps, through port widening,procedure uneventfull
VIEW IMAGE BANK
Young ophthalmologists retinal imaging society
Clinical cases
Clinical case of the month

Fish Tail flecks
A 55-year-old male patient was referred to our medical retina unit for bilateral vision loss occurred in the last year. Fundus examination revealed bilateral macular atrophy with foveal sparing surrounded by yellowish ‘fish tail flecks’ all over the posterior pole. SD-OCT, FAF, FA and ERG were performed. Genetic evaluation confirmed diagnosis of Stargardt Disease.
Read more